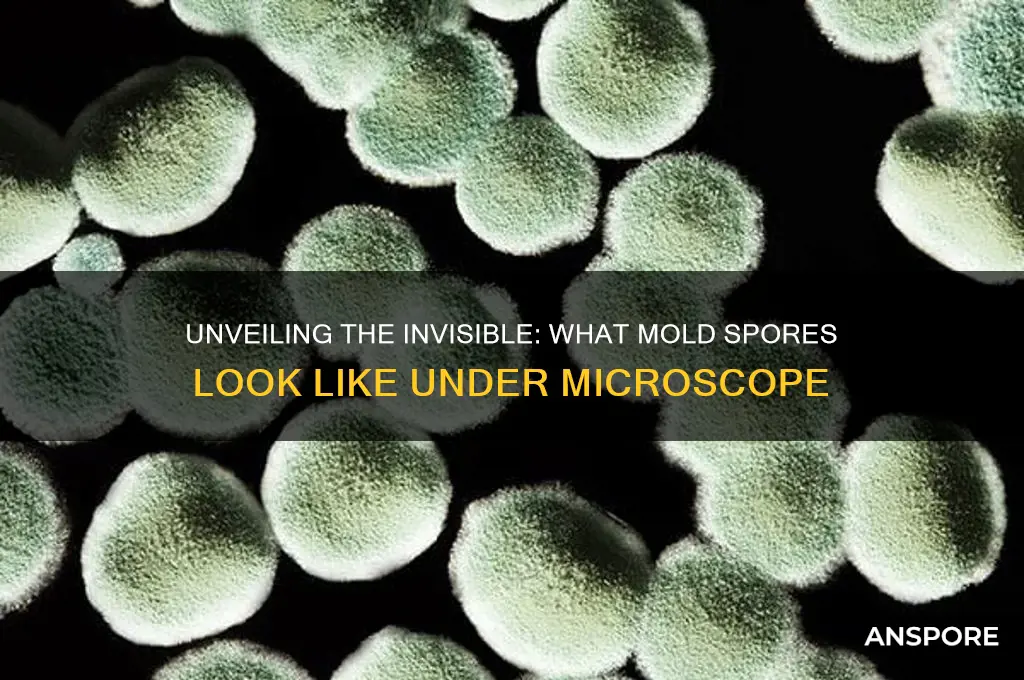
what does mold spores look like

Mold spores are microscopic, typically ranging from 2 to 100 microns in size, making them invisible to the naked eye. They appear as tiny, lightweight particles that can vary in shape, color, and texture depending on the mold species. While individual spores cannot be seen without magnification, a cluster of spores may manifest as a powdery or fuzzy substance on surfaces, often in shades of green, black, white, or brown. Under a microscope, mold spores reveal intricate structures, such as smooth, rough, or spiky surfaces, which aid in their identification. Understanding their appearance is crucial for detecting mold growth and addressing potential health or structural concerns.
| Characteristics | Values |
|---|---|
| Size | Typically 2-100 micrometers (μm) in diameter, though some can be smaller or larger. |
| Shape | Varies widely; can be spherical, oval, cylindrical, or irregular, depending on the mold species. |
| Color | Often transparent or lightly colored (e.g., green, black, white, brown, or gray) when viewed under a microscope. |
| Texture | Smooth or rough, depending on the species and environmental conditions. |
| Visibility | Invisible to the naked eye; requires a microscope (typically 400x magnification or higher) for observation. |
| Structure | Some spores have appendages (e.g., spines, hairs, or wings) that aid in dispersal. |
| Wall Thickness | Varies; some have thick, resistant walls (e.g., Aspergillus) for survival in harsh conditions. |
| Dispersal | Lightweight and easily airborne, allowing them to travel long distances. |
| Resistance | Highly resistant to environmental stresses, such as heat, cold, and desiccation. |
| Reproduction | Produced by mold fungi for asexual reproduction, often in large quantities. |
| Examples | Common mold spores include those from Aspergillus, Penicillium, Cladosporium, and Stachybotrys. |
Explore related products
What You'll Learn
- Color Variations: Mold spores range from green, black, white, to blue-ish hues
- Size and Shape: Typically microscopic, round or oval, visible in clusters
- Texture Appearance: Powdery, fuzzy, or slimy depending on mold type
- Common Types: Aspergillus (green), Stachybotrys (black), Penicillium (blue-green)
- Visibility: Often invisible alone, seen as colonies or discoloration

Color Variations: Mold spores range from green, black, white, to blue-ish hues
Mold spores, the microscopic reproductive units of fungi, exhibit a surprising array of colors, each hinting at the species and potential risks they pose. Green spores, often associated with *Cladosporium* or *Aspergillus*, are among the most common. These hues can range from pale lime to deep forest, depending on the spore's maturity and environmental conditions. While not all green molds are harmful, some can trigger allergies or respiratory issues, especially in sensitive individuals. For instance, *Aspergillus* spores, when inhaled in large quantities, can lead to aspergillosis, a condition particularly dangerous for those with compromised immune systems.
Black mold spores, typically linked to *Stachybotrys chartarum*, are notorious for their potential health hazards. These spores often appear as dark, inky dots, clustering in damp, water-damaged areas like basements or bathrooms. Unlike their green counterparts, black mold spores are less about allergies and more about toxic effects. Mycotoxins produced by *Stachybotrys* can cause severe symptoms, including chronic coughing, skin irritation, and even neurological issues. If you spot black mold, immediate remediation is crucial—use protective gear, ensure proper ventilation, and consider professional removal for large infestations.
White mold spores, such as those from *Penicillium* or *Fusarium*, often blend into their surroundings, making them harder to detect. These spores thrive in cooler, less humid environments compared to their black or green relatives. While *Penicillium* is famous for its role in antibiotic production, certain strains can cause food spoilage or allergic reactions. *Fusarium*, on the other hand, is a plant pathogen but can also infect humans, particularly through contaminated grains. To prevent white mold growth, maintain low humidity levels (below 50%) and inspect stored food regularly for signs of spoilage.
Blue-ish mold spores, though less common, are no less intriguing. Species like *Penicillium* (again, in certain strains) or *Trichoderma* can display shades of blue or blue-green. These molds often grow on decaying organic matter or in soil. While *Trichoderma* is beneficial in some contexts, such as biocontrol in agriculture, it can also cause allergies or infections in humans. Interestingly, the blue pigment in some molds is due to the presence of anthraquinones, compounds with antimicrobial properties. If you encounter blue mold, avoid direct contact and dispose of contaminated materials safely, especially if they are porous.
Understanding the color variations of mold spores is not just an academic exercise—it’s a practical tool for identifying potential risks and taking appropriate action. Green, black, white, or blue, each hue tells a story about the mold’s species, habitat, and potential impact on health. By recognizing these colors and their implications, you can better protect your home, health, and environment. Always remember: when in doubt, consult a professional for accurate identification and safe removal.
Identifying Black Mold Spores on Leather: Appearance and Detection Tips
You may want to see also

Size and Shape: Typically microscopic, round or oval, visible in clusters
Mold spores are masters of stealth, often eluding detection due to their minuscule size. Typically measuring between 2 and 100 micrometers in diameter, they fall squarely within the microscopic realm, invisible to the naked eye. This diminutive stature is a strategic adaptation, allowing them to travel effortlessly through the air, water, and even on clothing, ensuring their widespread dispersal. For context, a human hair averages around 75 micrometers in width, making most mold spores significantly smaller. Despite their invisibility individually, their collective presence can become apparent under the right conditions.
The shape of mold spores is equally intriguing, often described as round or oval, though variations exist depending on the species. This uniformity in shape is not arbitrary; it enhances their aerodynamic properties, facilitating airborne travel. Imagine a dandelion seed, designed to catch the wind—mold spores operate on a similar principle, albeit on a microscopic scale. When viewed under a microscope, these spores reveal a surprising elegance, their smooth, curved surfaces reflecting light in ways that can aid in identification. However, their true impact becomes evident when they aggregate.
Clusters of mold spores are where their presence transitions from invisible to noticeable. While individual spores remain undetectable, they often settle and multiply in groups, forming visible colonies. These clusters can appear as speckled patches, fuzzy growths, or even powdery substances, depending on the mold type and environmental conditions. For instance, *Aspergillus* spores may cluster in a velvety texture, while *Penicillium* can form a more granular appearance. Recognizing these clusters is crucial, as they signal not just the presence of mold but also its potential to spread and cause harm.
Practical detection of mold spore clusters requires vigilance and the right tools. In households, common areas like bathrooms, basements, and kitchens are prime locations for clustering due to moisture accumulation. Using a magnifying glass or a simple microscope can reveal early signs of aggregation before they become full-blown infestations. For more precise identification, air quality tests or mold test kits can quantify spore counts, providing actionable data. Addressing clusters promptly—through improved ventilation, dehumidification, or professional remediation—can prevent health risks and structural damage. Understanding the size, shape, and clustering behavior of mold spores empowers individuals to act decisively against these microscopic invaders.
Extending Mushroom Spores Lifespan: Fridge Storage Tips and Duration
You may want to see also

Texture Appearance: Powdery, fuzzy, or slimy depending on mold type
Mold spores, though microscopic, manifest in visible colonies that betray their presence through distinct textures. These textures—powdery, fuzzy, or slimy—are not arbitrary but directly tied to the mold species and its environment. For instance, Aspergillus, a common indoor mold, often appears as a fine, talcum-like powder, while Penicillium presents a velvety, fuzzy surface. Understanding these textures is crucial for identification and remediation, as each type demands specific handling methods.
Consider the powdery mold, often found on food items like bread or cheese. This texture results from the mold’s rapid spore production, creating a dry, easily dispersible layer. A practical tip: avoid touching powdery mold with bare hands, as spores can become airborne and inhaled, posing health risks. Instead, use a damp cloth to contain the spores before disposal. In contrast, fuzzy mold, like that on citrus fruits or bathroom walls, has a more anchored structure, making it less likely to disperse unless disturbed.
Slime molds, such as those in the Physarum genus, defy expectations with their wet, gelatinous appearance. These molds thrive in damp, organic-rich environments and can resemble a translucent, gooey mass. While less common indoors, they highlight the diversity of mold textures and the importance of moisture control. A cautionary note: slimy molds can be mistaken for water damage, but their presence indicates prolonged dampness, a breeding ground for other mold types.
Comparatively, the texture of mold colonies also reflects their growth stage and nutrient source. Powdery molds often dominate in the early stages, while fuzzy molds emerge as colonies mature. Slimy molds, however, maintain their wet texture throughout, adapting to their environment by moving toward food sources. This adaptability underscores the need for prompt action: address moisture issues immediately to prevent mold proliferation, regardless of its texture.
In summary, the texture of mold—powdery, fuzzy, or slimy—is a diagnostic feature that guides both identification and response. Powdery molds require careful containment, fuzzy molds demand thorough cleaning, and slimy molds necessitate moisture elimination. By recognizing these textures, you can tailor your approach to effectively manage mold, safeguarding both health and property.
Understanding Spore Prints: A Beginner's Guide to Mushroom Identification
You may want to see also
Explore related products

Common Types: Aspergillus (green), Stachybotrys (black), Penicillium (blue-green)
Mold spores are microscopic, but their colonies reveal distinct colors and textures that help identify common types. Among the most prevalent are Aspergillus (green), Stachybotrys (black), and Penicillium (blue-green). Each type thrives in specific conditions and poses unique risks, making their visual identification crucial for timely remediation.
Aspergillus, often green or grayish-green, is a versatile mold found indoors and outdoors. It flourishes in warm, damp environments like air conditioning systems, insulation, and decaying organic matter. While some species are harmless, others produce toxic compounds called aflatoxins, which can cause respiratory issues or allergic reactions. To prevent Aspergillus growth, maintain indoor humidity below 50% and promptly repair water leaks. Regularly inspect HVAC systems and ensure proper ventilation in basements and attics.
Stachybotrys, commonly known as black mold, appears dark green or black and thrives on cellulose-rich materials like drywall, wood, and paper. It requires prolonged moisture exposure to grow, often appearing after water damage or flooding. Stachybotrys is notorious for producing mycotoxins, which can lead to severe health issues, including chronic sinusitis and respiratory problems. If detected, professional remediation is recommended, as disturbing the mold can release spores into the air. Use protective gear, such as gloves and masks, when handling affected materials.
Penicillium, characterized by its blue-green or yellowish-green appearance, is widespread in soil, food, and indoor environments. It grows rapidly on water-damaged materials like wallpaper, carpet, and fabrics. While some Penicillium species are beneficial (e.g., producing antibiotics), others can cause allergies or infections, particularly in immunocompromised individuals. To control Penicillium, address moisture issues promptly, clean visible mold with a detergent solution, and discard porous materials that cannot be thoroughly cleaned.
In summary, recognizing the colors and habitats of Aspergillus (green), Stachybotrys (black), and Penicillium (blue-green) is essential for effective mold management. Each type demands specific prevention and remediation strategies, from humidity control to professional intervention. Early identification not only protects your property but also safeguards your health from the unique risks each mold poses.
Optimal Autoclave Spore Testing Frequency for Reliable Sterilization Results
You may want to see also

Visibility: Often invisible alone, seen as colonies or discoloration
Mold spores, on their own, are microscopic entities, typically ranging from 2 to 100 microns in size, making them invisible to the naked eye. This invisibility is both a blessing and a challenge. While it means you won’t spot individual spores floating in the air or settling on surfaces, it also implies that their presence can go unnoticed until they multiply into visible colonies. Understanding this invisibility is crucial for early detection, as mold growth can escalate quickly in damp, humid environments.
When mold spores land on a suitable surface and find the right conditions—moisture, warmth, and organic material—they begin to grow and form colonies. These colonies are what make mold visible. They often appear as fuzzy, discolored patches on walls, ceilings, or other surfaces. The color of these colonies can vary widely, from black and green to white and orange, depending on the mold species. For instance, *Stachybotrys chartarum*, commonly known as black mold, appears as dark clusters, while *Aspergillus* species may present as powdery, greenish-gray spots. Recognizing these visual cues is the first step in addressing a mold problem.
Discoloration is another telltale sign of mold growth, often appearing before the texture of a colony becomes apparent. This discoloration can manifest as streaks, spots, or blotches on surfaces like drywall, wallpaper, or fabric. It’s important to note that not all discoloration is mold-related—water stains or aging materials can mimic mold—but persistent, unexplained discoloration in damp areas should raise red flags. Using a moisture meter to check for hidden dampness behind walls or under flooring can help confirm whether mold is the culprit.
To effectively detect mold in its early stages, rely on both visual inspection and environmental awareness. Regularly examine areas prone to moisture, such as bathrooms, basements, and kitchens, for any signs of discoloration or texture changes. If you suspect mold but can’t see it, consider using a mold test kit or hiring a professional to conduct air quality testing. These methods can detect invisible spores before they form visible colonies, allowing for proactive remediation. Early intervention not only prevents structural damage but also safeguards indoor air quality and health.
C. Diff Spores Survival: How Long Do They Live on Surfaces?
You may want to see also
Frequently asked questions
Mold spores are typically invisible to the naked eye, as they are microscopic, ranging from 2 to 100 microns in size. They become visible only when they grow into colonies, appearing as discolored patches on surfaces.
Mold spores themselves are usually colorless or translucent, but when they grow into colonies, they can appear in various colors, such as black, green, white, brown, or even pink, depending on the mold species.
Yes, mold spores can be seen under a microscope. They appear as tiny, often spherical or oval-shaped particles, and their structure can vary depending on the type of mold.
Mold spores can sometimes be mistaken for dust, but they are distinct. Dust particles are larger and more irregular in shape, while mold spores are smaller, more uniform, and often clump together in colonies when visible.































